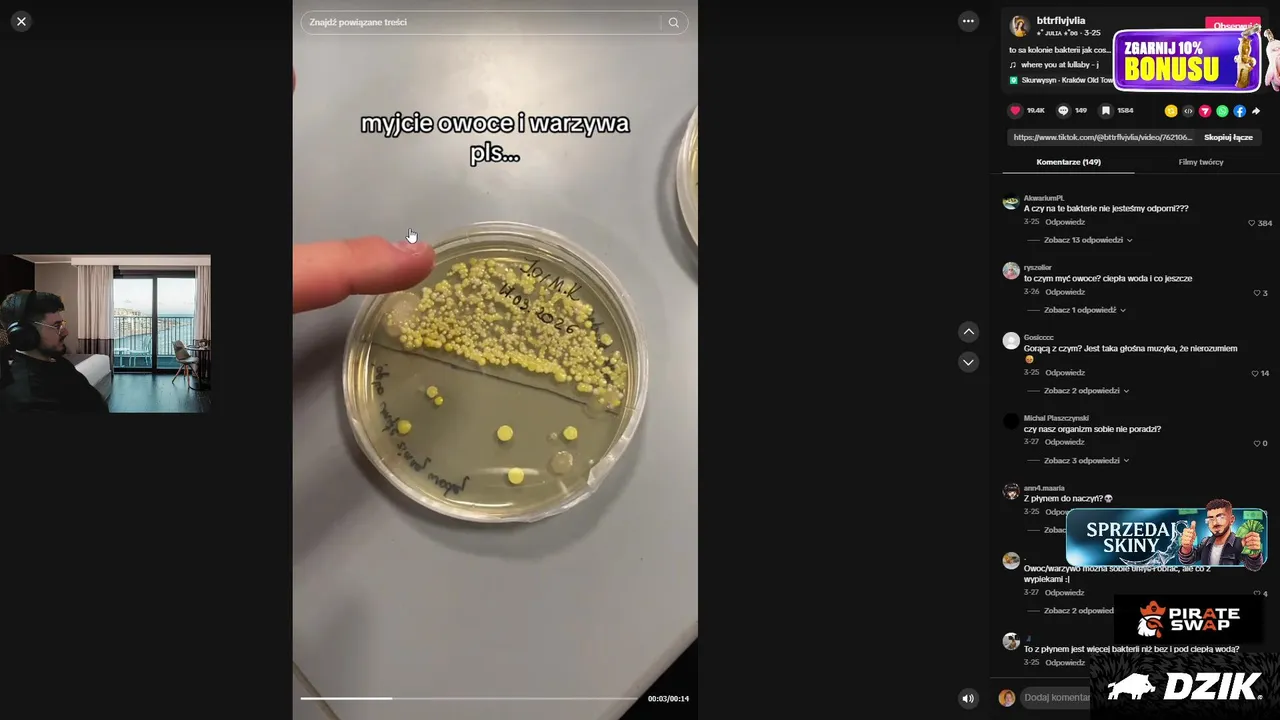

Language
-
1
العربية on periscope.tv
Viewers: 157331
Duration: 57 min. -
2
 Drb7h
on kick.com
Drb7h
on kick.com
Viewers: 53782
Duration: 42 min. -
3
 HasanAbi
on twitch.tv
HasanAbi
on twitch.tv
Viewers: 35726
Duration: 140 min. -
4
 leva2k
on twitch.tv
leva2k
on twitch.tv
Viewers: 31208
Duration: 61 min. -
5
 eliasn97
on twitch.tv
eliasn97
on twitch.tv
Viewers: 26754
Duration: 23 min. -
6
 Jahrein
on kick.com
Jahrein
on kick.com
Viewers: 14123
Duration: 54 min. -
7
ا لـحـدث on periscope.tv
Viewers: 13948
Duration: 2 min. -
8
 angryginge13
on twitch.tv
angryginge13
on twitch.tv
Viewers: 10134
Duration: 182 min. -
9
 Chips
on kick.com
Chips
on kick.com
Viewers: 9156
Duration: 20 min. -
10
 TYRIQUEHYDE
on twitch.tv
TYRIQUEHYDE
on twitch.tv
Viewers: 8755
Duration: 3 min. -
11
 elxokas
on twitch.tv
elxokas
on twitch.tv
Viewers: 8691
Duration: 112 min. -
12
 clavicular
on kick.com
clavicular
on kick.com
Viewers: 8670 -
13
 JesusAVGN
on kick.com
JesusAVGN
on kick.com
Viewers: 8282
Duration: 54 min. -
14
 Cellbit
on twitch.tv
Cellbit
on twitch.tv
Viewers: 7722
Duration: 20 min. -
15
NEEXcsgo
on kick.com
NEEXcsgo
on kick.com
Viewers: 7043
Duration: 54 min. -
16
 OdedSVR
on kick.com
OdedSVR
on kick.com
Viewers: 6908
Duration: 6 min. -
17
 ilkerfirat
on kick.com
ilkerfirat
on kick.com
Viewers: 6882
Duration: 54 min. -
18
 SiDeRaL
on kick.com
SiDeRaL
on kick.com
Viewers: 6864 -
19
 bendadonnn
on twitch.tv
bendadonnn
on twitch.tv
Viewers: 6083
Duration: 53 min. -
20
 Kingteka
on kick.com
Kingteka
on kick.com
Viewers: 6054
Duration: 54 min. -
21
 fregepaul
on twitch.tv
fregepaul
on twitch.tv
Viewers: 6047
Duration: 712 min. -
22
 Nico_la
on twitch.tv
Nico_la
on twitch.tv
Viewers: 6047
Duration: 106 min. -
23
 5opka
on twitch.tv
5opka
on twitch.tv
Viewers: 5636
Duration: 44 min. -
24
 konygebony
on twitch.tv
konygebony
on twitch.tv
Viewers: 5621
Duration: 213 min. -
25
 Luisormenoa27
on kick.com
Luisormenoa27
on kick.com
Viewers: 5606
Duration: 54 min. -
26
 ZGOUGOU13
on kick.com
ZGOUGOU13
on kick.com
Viewers: 5485
Duration: 12 min. -
27
 youladecadd
on twitch.tv
youladecadd
on twitch.tv
Viewers: 5459
Duration: 55 min. -
28
 ElMacarius
on kick.com
ElMacarius
on kick.com
Viewers: 5218
Duration: 54 min. -
29
 Shylily
on twitch.tv
Shylily
on twitch.tv
Viewers: 5199
Duration: 218 min. -
30
 mokrysuchar
on kick.com
mokrysuchar
on kick.com
Viewers: 5124
Duration: 54 min. -
31
 GamerBrother
on twitch.tv
GamerBrother
on twitch.tv
Viewers: 5071
Duration: 32 min. -
32
 Jellyfruciczek
on kick.com
Jellyfruciczek
on kick.com
Viewers: 4994
Duration: 20 min. -
33
 abzou
on kick.com
abzou
on kick.com
Viewers: 4834 -
34
 erobb221
on twitch.tv
erobb221
on twitch.tv
Viewers: 4738
Duration: 15 min. -
35
HardPlay on vkvideo.ru
Viewers: 4738
Duration: 165 min. -
36
 あー𓂃🥀𓈒𓏸ᒼᑋªⁿ
on 17.live
あー𓂃🥀𓈒𓏸ᒼᑋªⁿ
on 17.live
Viewers: 4601
Duration: 388 min. -
37
 husamviyuviyu
on kick.com
husamviyuviyu
on kick.com
Viewers: 4447
Duration: 54 min. -
38
 niter
on kick.com
niter
on kick.com
Viewers: 4392
Duration: 54 min. -
39
 ManuuXO
on twitch.tv
ManuuXO
on twitch.tv
Viewers: 4317
Duration: 47 min. -
40
 Jolavanille
on kick.com
Jolavanille
on kick.com
Viewers: 4256
Duration: 16 min. -
41
 MISTERARTHER
on twitch.tv
MISTERARTHER
on twitch.tv
Viewers: 4083
Duration: 153 min. -
42
 ももchan_JCE
on 17.live
ももchan_JCE
on 17.live
Viewers: 3644
Duration: 566 min. -
43
 uraniumrr
on twitch.tv
uraniumrr
on twitch.tv
Viewers: 3599
Duration: 84 min. -
44
 fishtank
on kick.com
fishtank
on kick.com
Viewers: 3541 -
45
 cutierover
on twitch.tv
cutierover
on twitch.tv
Viewers: 3528
Duration: 326 min. -
46
 Azdus
on kick.com
Azdus
on kick.com
Viewers: 3490 -
47
 TheWitty21
on kick.com
TheWitty21
on kick.com
Viewers: 3475
Duration: 40 min. -
48
 うさぎ_17
on 17.live
うさぎ_17
on 17.live
Viewers: 3398
Duration: 2661 min. -
49
 まこ吉👁👄👁mako
on 17.live
まこ吉👁👄👁mako
on 17.live
Viewers: 3253
Duration: 602 min. -
50
 RESTT
on kick.com
RESTT
on kick.com
Viewers: 3212
Duration: 40 min. -
51
 sheviii2k
on twitch.tv
sheviii2k
on twitch.tv
Viewers: 3178
Duration: 444 min. -
52
 vald
on twitch.tv
vald
on twitch.tv
Viewers: 3177
Duration: 91 min. -
53
 Canbequit
on kick.com
Canbequit
on kick.com
Viewers: 3095
Duration: 54 min. -
54
 thimagroo
on twitch.tv
thimagroo
on twitch.tv
Viewers: 3088
Duration: 335 min. -
55
 Carola
on twitch.tv
Carola
on twitch.tv
Viewers: 3072
Duration: 91 min. -
56
 ElChiringuitoTV
on twitch.tv
ElChiringuitoTV
on twitch.tv
Viewers: 2989
Duration: 141 min. -
57
 ✨🧚🏻♀️Yuumin🍷🍇
on 17.live
✨🧚🏻♀️Yuumin🍷🍇
on 17.live
Viewers: 2879
Duration: 598 min. -
58
 Brunenger
on kick.com
Brunenger
on kick.com
Viewers: 2864 -
59
 Dodo
on kick.com
Dodo
on kick.com
Viewers: 2842
Duration: 54 min. -
60
 iceicell
on twitch.tv
iceicell
on twitch.tv
Viewers: 2838
Duration: 74 min. -
61
 umurafann
on kick.com
umurafann
on kick.com
Viewers: 2780
Duration: 54 min. -
62
 Cell
on kick.com
Cell
on kick.com
Viewers: 2757
Duration: 54 min. -
63
 YUY_IX
on twitch.tv
YUY_IX
on twitch.tv
Viewers: 2667
Duration: 97 min. -
64
 gabepeixe
on twitch.tv
gabepeixe
on twitch.tv
Viewers: 2663
Duration: 2 min. -
65
 Nicistemmler
on twitch.tv
Nicistemmler
on twitch.tv
Viewers: 2562
Duration: 706 min. -
66
 DIMAGORDEY_
on twitch.tv
DIMAGORDEY_
on twitch.tv
Viewers: 2548
Duration: 227 min. -
67
 ChristinaandAmber
on twitch.tv
ChristinaandAmber
on twitch.tv
Viewers: 2449
Duration: 74 min. -
68
 Pauleta_Twitch
on twitch.tv
Pauleta_Twitch
on twitch.tv
Viewers: 2412
Duration: 35 min. -
69
 D1ceDevil
on twitch.tv
D1ceDevil
on twitch.tv
Viewers: 2325
Duration: 19 min. -
70
 Inkosiyamandebele
on twitch.tv
Inkosiyamandebele
on twitch.tv
Viewers: 2258
Duration: 45 min. -
71
 NiklasWilson
on twitch.tv
NiklasWilson
on twitch.tv
Viewers: 2240
Duration: 21 min. -
72
 helydia
on twitch.tv
helydia
on twitch.tv
Viewers: 2239
Duration: 136 min. -
73
 ReneKreher
on twitch.tv
ReneKreher
on twitch.tv
Viewers: 2151
Duration: 1961 min. -
74
 KroozzNS
on kick.com
KroozzNS
on kick.com
Viewers: 2039
Duration: 8 min. -
75
Тот самый Царевич on vkvideo.ru
Viewers: 2021
Duration: 169 min. -
76
 CottontailVA
on twitch.tv
CottontailVA
on twitch.tv
Viewers: 2004
Duration: 136 min. -
77
 HYVER
on twitch.tv
HYVER
on twitch.tv
Viewers: 2003
Duration: 110 min. -
78
 itsAssiTV
on twitch.tv
itsAssiTV
on twitch.tv
Viewers: 1990
Duration: 147 min. -
79
 therealescro
on kick.com
therealescro
on kick.com
Viewers: 1982 -
80
 Snopey
on twitch.tv
Snopey
on twitch.tv
Viewers: 1951
Duration: 155 min. -
81
 JuniorHealy
on twitch.tv
JuniorHealy
on twitch.tv
Viewers: 1928
Duration: 202 min. -
82
 ZakvielChannel
on twitch.tv
ZakvielChannel
on twitch.tv
Viewers: 1903
Duration: 19 min. -
83
 jakeydavies
on twitch.tv
jakeydavies
on twitch.tv
Viewers: 1893
Duration: 242 min. -
84
 loveBASTOS
on twitch.tv
loveBASTOS
on twitch.tv
Viewers: 1861
Duration: 126 min. -
85
 GrenBaud
on twitch.tv
GrenBaud
on twitch.tv
Viewers: 1825
Duration: 33 min. -
86
 AliBumayeTV
on twitch.tv
AliBumayeTV
on twitch.tv
Viewers: 1815
Duration: 90 min. -
87
 NotQuiteLikeDuB
on twitch.tv
NotQuiteLikeDuB
on twitch.tv
Viewers: 1786
Duration: 23 min. -
88
 coachlim
on twitch.tv
coachlim
on twitch.tv
Viewers: 1774
Duration: 90 min. -
89
 ELCUERVOSZ
on kick.com
ELCUERVOSZ
on kick.com
Viewers: 1760
Duration: 54 min. -
90
 MadAtTheInternet
on kick.com
MadAtTheInternet
on kick.com
Viewers: 1697
Duration: 54 min. -
91
 Bandospapa
on twitch.tv
Bandospapa
on twitch.tv
Viewers: 1679
Duration: 89 min. -
92
 長腿哈比
on 17.live
長腿哈比
on 17.live
Viewers: 1673
Duration: 135 min. -
93
한갱 on afreecatv.com
Viewers: 1657
Duration: 496 min. -
94
 shimitchan2525
on kick.com
shimitchan2525
on kick.com
Viewers: 1652 -
95
 kuhlmanvirallinen
on kick.com
kuhlmanvirallinen
on kick.com
Viewers: 1639 -
96
 MasterSnakou
on twitch.tv
MasterSnakou
on twitch.tv
Viewers: 1635
Duration: 81 min. -
97
 🩵寶包👶BoBo🍼
on 17.live
🩵寶包👶BoBo🍼
on 17.live
Viewers: 1634
Duration: 449 min. -
98
 pajalock
on kick.com
pajalock
on kick.com
Viewers: 1600 -
99
 Apricot
on twitch.tv
Apricot
on twitch.tv
Viewers: 1577
Duration: 280 min. -
100
 Move_Mind
on twitch.tv
Move_Mind
on twitch.tv
Viewers: 1576
Duration: 86 min.
Items 1-100 out of 8137 displayed.
Pages: next →